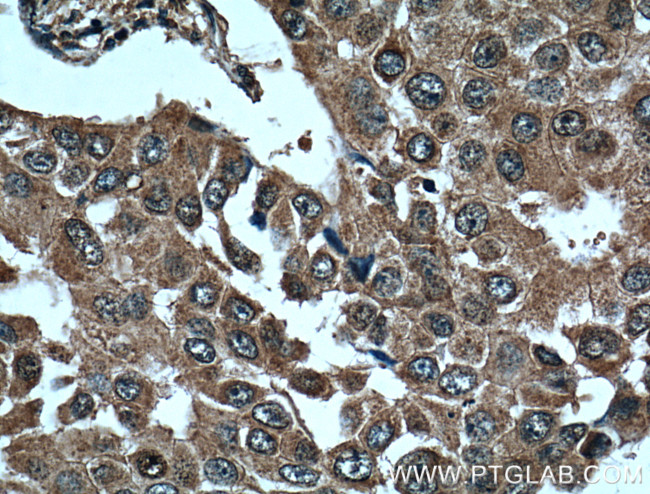
L2HGDH Antibody in Immunohistochemistry (Paraffin) (IHC (P))

Search
Proteintech
L2HGDH Monoclonal Antibody (3D11C2)
{{$productOrderCtrl.translations['antibody.pdp.commerceCard.promotion.promotions']}}
{{$productOrderCtrl.translations['antibody.pdp.commerceCard.promotion.viewpromo']}}
{{$productOrderCtrl.translations['antibody.pdp.commerceCard.promotion.promocode']}}: {{promo.promoCode}} {{promo.promoTitle}} {{promo.promoDescription}}. {{$productOrderCtrl.translations['antibody.pdp.commerceCard.promotion.learnmore']}}
产品信息
66269-1-IG
种属反应
宿主/亚型
分类
类型
克隆号
抗原
偶联物
形式
浓度
规格
纯化类型
保存液
内含物
保存条件
运输条件
产品详细信息
Immunogen sequence: MVPALRYLV GACGRARGRF AGGSPGACGF ASGRPRPLCG GSRSASTSSF DIVIVGGGIV GLASARALIL RHPSLSIGVL EKEKDLAVHQ TGHNSGVIHS GIYYKPESLK AKLCVQGAAL LYEYCQQKGI SYKQCGKLIV AVEQEEIPRL QALYEKGLQN GVPGLRLIQQ EDIKKKEPYC RGLMAIDCPH TGIVDYRQVA LSFAQDFQEA GGSVLTNFEV KGIEMAKESP SRSIDGMQYP IVIKNTKGEE IRCQYVVTCA GLYSDRISEL SGCTPDPRIV PFRGDYLLLK PEKCYLVKGN IYPVPDSRFP FLGVHFTPRM DGSIWLGPNA VLAFKREGYR PFDFSATDVM DI (1-351 aa encoded by BC006117)
靶标信息
This gene encodes L-2-hydroxyglutarate dehydrogenase, a FAD-dependent enzyme that oxidizes L-2-hydroxyglutarate to alpha-ketoglutarate in a variety of mammalian tissues. Mutations in this gene cause L-2-hydroxyglutaric aciduria, a rare autosomal recessive neurometabolic disorder resulting in moderate to severe mental retardation.
仅用于科研。不用于诊断过程。未经明确授权不得转售。
篇参考文献 (0)
生物信息学
蛋白别名: 2-hydroxyglutarate dehydrogenase; alpha-hydroxyglutarate oxidoreductase; alpha-ketoglutarate reductase; Duranin; FLJ12618; L-2-hydroxyglutarate dehydrogenase, mitochondrial; L-alpha-hydroxyglutarate dehydrogenase; unnamed protein product
基因别名: C14orf160; L2HGA; L2HGDH
UniProt ID: (Human) Q9H9P8
Entrez Gene ID: (Human) 79944, (Pig) 100152180